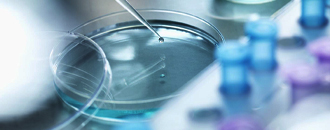
Laboratory Consumables

Who are
WE?
We are the team of professionals with more than 10 years of field experience in field of Coal, Mineral, Material, Water Analysis, Environmental Analysis, Medical, Biotechnology, Laboratory and Educational Sectors.
We are the team of professionals with more than 10 years of field experience who understand what customer needs...
We are pleased to introduce ourselves as Metaverse scientific & laboratory equipment trading co. LLC is the Dubai, UAE based trading company. We are the team of professionals with more than 10 years of field experience who understand what customer needs and trying to full fill those requirements in appropriate span of time with suitable best price.


10
Years of Experience
Number of
People Benefitted
03
Certificates Holded








Fulfillment
Our company equipped with critical spares to address emergencies and ensure maximum uptimes of the equipment.
Guidance
We provide an effective after sales service and also provide a strong technical support, post the warranty period,Understanding this..
Beingness
Understanding this, we have built an effective customer support process to address the post sales needs of customers. For any support request..
Guidance
Service effectiveness and customer satisfaction is one of the key differentiators of organizations and for ensuring long
We supply best quality with affordable price of laboratory equipment and analytical instruments for scientific, R&D, educational laboratories across the Middle East. We are best supplier of Laboratory Equipment, Scientific Instrument, School Lab..

Analytical instruments include mass spectrometers, chromatographs (e.g. GC and HPLC), titrators, spectrometers (e.g. AAS, X-ray, and fluorescence), particle size analyzers, rheometers, elemental analyzers (e.g. salt analyzers, CHN analyzers), thermal analyzers..

We are the leading Supplier, exporter, wholesaler and trader of Medical Equipments. These products are developed with the use of high-grade raw material and technically advanced machines at our. We supply medical equipment all over the world..

We are the best supplier of 96 Well Plate Centrifuge With Modern Microprocessor, Autoclave,Vertical,Biological Safety Cabinet,Blood Bank Refrigerators,Centrifuge 15000 Rpm,Clinical

Metaverse scientific supply the laboratory equipment for the school labs of primary school labs Between standard 5 to 8, students get the knowledge of the basic lab practice and get to know about their uses..

We Supply Water Quality Testing Equipment · Handheld Meters · Multiparameter Sondes · CTD · Automatic Water Samplers · Single Parameter Sensors · Online / Process Monitors.

High Pressure Equipment Company designs and manufactures a broad range of pressure vessels and reactors for both bench-scale and pilot plant applications..

Sample Preparation Equipment is oriented toward smaller scale particle size reduction and sample division activities that are commonly associated with ...

Furnaces heat air and distribute the heated air through the house using ducts. Boilers heat water, and provide either hot water or steam for heating..

Laboratory Equipments available on Revalab encompasses Desiccator, Hotplate, Micropipettes, Pipetting aids, Circulating baths and Centrifuge, Weighing balances..

We are the best Wholesales Laboratory consumables suppliers, high - quality & fast delivery, order. Our supplied plastic consumables are precisely manufactured..
We are Laboratory Chemicals – India, Manufacturer and exporter of laboratory chemicals, hplc chemicals, reagents, imported chemicals from India..

We associate has to provide the perfect service delivery for customer and the techniques required for the closing of sale. Assessment

We work to satisfy these customers by delivering a product or service that addresses these needs at the time customers want it.

Customized Solutions for Unique Needs. Laboratory Equipment consultation. Design, development and distribution. Direct import of equipment and spare parts

















